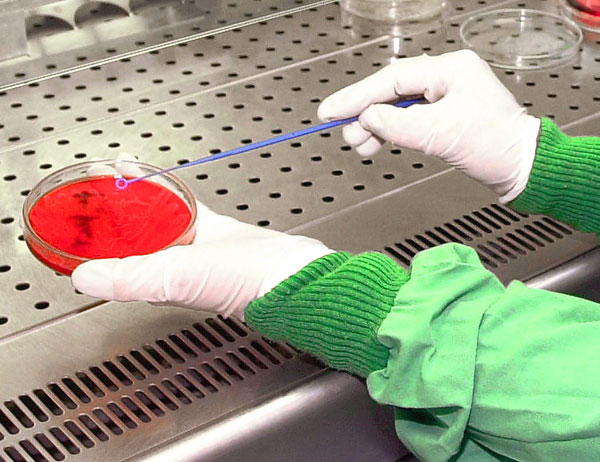
Las placas petri, el gran invento de la microbiología

En cualquier laboratorio de microbiología del mundo podemos encontrar unas pequeñas cajas circulares transparentes compuestas por dos piezas conocidas como placas de Petri. Su nombre se debe a un científico que, gracias a esta genial idea, ha permitido a miles de científicos cultivar hongos, bacterias y todo tipo de microorganismos en condiciones controladas.
Julius Richard Petri nació el 31 de mayo de 1852, y aunque no logró ningún premio Nobel fue un científico fundamental en la historia de la microbiología. Tras estudiar en la academia militar Kaiser Wilhelm-Akademie para médicos y doctorarse en la Clínica Charité de Berlín, en 1876 estuvo trabajando para el famoso Robert Koch, premio Nobel de Fisiología y Medicina en 1905. Y fue precisamente mientras colaboraba con el famoso científico alemán cuando inventó su famosa placa de Petri.
Básicamente unió dos tapas redondas de vidrio transparente que permitían aislar las muestras de distintos microorganismos y hacerlos crecer en condiciones controladas. Lo que parecía algo simple y actualmente más que normal, en su momento fue una auténtica revolución para la microbiología y para la medicina.
Y es que durante el siglo XIX grandes epidemias muy contagiosas estaban mermando la población de medio mundo. Gracias a las placas de Petri se consiguieron aislar los microorganismos que provocaban enfermedades como la cólera o la difteria, encontrando posteriormente la cura a los mismos.
Las placas petri, el gran invento de la microbiología
En cualquier laboratorio de microbiología del mundo podemos encontrar unas pequeñas cajas circulares transparentes compuestas por dos piezas conocidas como placas de Petri. Su nombre se debe a un científico que, gracias a esta genial idea, ha permitido a miles de científicos cultivar hongos, bacterias y todo tipo de microorganismos en condiciones controladas.